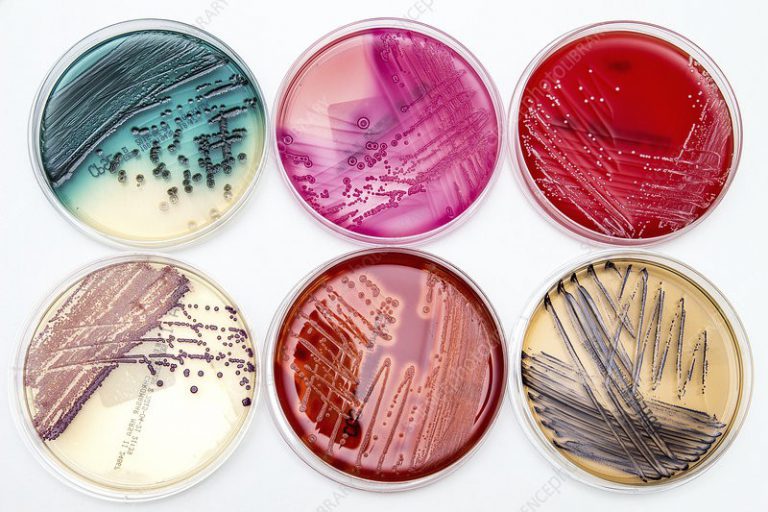
انواع محیط های کشت پرکاربرد

انواع محیط های کشت پرکاربرد
محیط های کشت محیطهایی هستند که برای کشت سلولهای و انواع میکروبها مورد استفاده قرار می گیرند. محیطهای کشت انواع مختلف و متفاوتی دارند که بسته به کاربرد میتوان از هرکدام آنها استفاده کرد. در مقاله پیشرو به معرفی انواع محیطهای کشت و کاربردهای آنها خواهیم پرداخت. فروشگاه اینترنتی تمادکالا در زمینه فروش محیط کشت با قیمت مناسب فعالیت می کند.
محیط کشت چیست؟
به طور کلی محیط کشت به محیطهایی گفته میشود که به صورت تخصصی برای رشد و تکثیر باکتریها یا سلولها تهیه شده اند و برای این منظور مورد استفاده قرار میگیرند. این محیط ها حاوی مواد خاصی هستند که محیط را برای رشد و تکثیر سلولها مهیا می کنند. از این مواد میتوان به قندها، نمکها، آب و غیره اشاره کرد.
برای کسب اطلاعات بیشتر در رابطه با محیطهای کشت می توانید به مقاله “محیط کشت چیست؟” مراجعه فرمایید.
قبل از بررسی محیط های کشت لازم است تا با ماده ای به نام آگار آشنا شویم.

آگار چیست؟
آگار ماده ای پلی ساکاریدی است که از نوعی جلبک قرمز دریایی تهیه می شود. این ماده در 95 درچه ذوب و در 43 درجه منعقد می شود. بدلیل اینکه دمای کشت بیشتر سلولها و باکتری ها در حدود 37 درجه سانتیگراد است، این ماده کاربرد بسیار زیادی در محیط های کشت دارد.
انواع دسته بندی محیط های کشت
در یک دسته بندی کلی محیطهای کشت را از نظر نحوه تهیه به سه گروه تقسیم بندی می کنند:
- محیط کشت مایع با آبوشتی(Broth or Liquid Media): این محیط ها فاقد آگار هستند و تنها در فلاسک یا لوله آزمایش استفاده می شوند. مانند محیط کشت Nutrient Broth
- محیط کشت جامد(Solid Media): این محیطها حاوی آگار هستند که بعد از سرد شدن منعقد می شود. از این محیط کشت ها درون لوله آزمایش یا پلیت استفاده می شود. مانند محیط کشت TSI
- محیط کشت نیمه جامد(Semi Solid Media): این گونه محیط ها در ترکیب خود مقدار کمی آگار دارند و به طور کامل منعقد نمی شوند؛ به حالت نیمه جامد باقی می مانند. مانند محیط کشت SIM
محیط کشت ها از نظر کاربرد و مواد تشکیل دهنده نیز به چند دسته تقسیم میشوند:
- محیط کشت عمومی/پایه(General purpose media/ Basic media): این محیط دارای کمترین میزان مواد غذایی برای رشد باکتری ها است. این محیط مبنای تهیه انواع محیط کشت است. این محیط از آنجایی که فاقد ماده ضد میکروب است، انواع و اقسام سلولها و باکتریها در آن رشد می کنند.
- محیط کشت غنی کننده(Enriched medis): محیطی بسیار مقوی است که دارای انواع مواد مورد نیاز برای رشد سلولها و باکتریهاست. این محیط برای رشد تعداد زیادی از سلولها و باکتری ها مناسب است.
- محیط کشت انتخابی(Selective media): این محیطهای کشت به صورت تشخیصی هستند. انواع مختلف این محیط ها برای رشد سلولها و باکتری های خاصی مناسب هستند.
- محیط کشت افتراقی(Differential/ indicator medium): این محیط ها برای جدا و ایزوله کردن توع خاصی از سلولها یا باکتری ها مناسب هستند. این محیط ها برای جدا کردن سلولها قابل استفاده هستند.
- محیط کشت کامل(Complete media): این محیط تمامی موارد مورد نیاز برای رشد باکتری ها و سلولها را داراست و مواد ضد میکروبی ندارد. این محیط ها هیچگونه مهارکنند و اندیکاتور(شاخص) ندارند و با رشد باکتری های مختلف روی آنها هیچ تغییر رنگی مشاهده نمی شود.
دسته بندی های دیگری نیز وجود دارند که از حوصله این مقاله خارج است.
انواع محیط کشت پرکاربرد
در این قسمت انواع محیط کشت های پرکاربرد و کاربردهای هرکدامشان را معرفی خواهیم کرد. تعداد محیط کشت هایی که وجود دارند، بسیار زیاد است. به همین دلیل لیستی که در زیر مشاهده می شود، لیست کاملی نیست و تنها تلاش شده که انواع پرکاربرد محیطهای کشت خدمت شما معرفی شود.
محیط کشت نوترینت آگار(Nutrient Agar)
از ترکیب 2-1.5 درصد ماده آگار با آبگوشت بدست می آید. این محیط کشت مبنای تهیه انواع و اقسام محیط های کشت جامد مانند Chocolate agar و Blood agar است.
محیط کشت نوترینت براث(Nutrient Broth)
این محیط مبنای ساخت اکثر محیط های کشت است و از عصاره گوشت تهیه می شود. طرز تهیه آن به نوترینت آگار شبیه است. از آنجایی که آگار به صورت مایع ندارد، در لوله آزمایش تهیه می شود.
محیط کشت آگار خوندار(Blood Agar)
بیشتر نمونه های میکروب شناسی در این محیط تهیه می شوند. دلیل آن هم این است که این محیط از رشد بیشتر باکتری های سخت رشد حمایت می کند. پایداری محیط بلاد آگار در یخچال در حدود یک هفته است؛ البته در صورتی که از تبخیر آب آن جلوگیری شود، این پایداری افزایش مییابد.
محیط کشت شکلات آگار(Chocolate agar)
محیط کشت پایه آن حرارت می بیند و پس از استریل شدن به آن خون اضافه می شود. دمای بالای محیط کشت باعث تخریب گلبول های قرمز می شود که باعث تیره شدن محیط کشت میشود. در این محیط مواد غذایی و هموگلوبین زیادی(ناشی از تخریب گلبول های قرمز) موجود است که زمینه را برای کشت باکتری ها و سلولها فراهم می کند.
این محیط کشت برای رشد باکتری های هوازی و میکروارگانیسم هایی که با سختی رشد می کنند مناسب است.

فروش محیط کشت شکلات آگار
محیط کشت آگار مککانکی
این محیط کشت به صورت اختصاصی برای جداسازی باکتری های گرم منفی و شناسایی آنها به کار می رود. این محیط بدلیل داشتن املاح صفراوی از رشد باکتری های رم مثبت جلوگیری می کند. این محیط کشت یک محیط کشت انتخابی-افتراقی است.
فروش محیط کشت مک کانکی
محیط کشت OF آگار
این محیط کشت توانایی باکتری ها در اکسیداسیون یا تخمیر باکتری ها را می سنجد. این محیط کشت برای تشخیص باکتری هایی که توانایی تخمیر کربوهیدرات را دارند موثر است. باکتری های تخمیر کننده باعث اسیدی شدن محیط و در نتیجه آن زرد شدن رنگ شناساگر بروموتیمول آبی می شوند. این محیط های کشت نسبت به تابش شدید نور خورشید حساس هستند.
فروش محیط کشت OF آگار
محیط کشت کاتالاز تست آگار
باکتری های هوازی آنزیمی به نام کاتاز تولید میکنند که این آنزیم باکتری را از ترکیب اکسیدکننده H2O2 مصون می دارد. این محیط کشت برای تشخیص توانایی باکتری ها در تولید آنزیم کاتالاز و به نوعی تشخیص باکتری های هوازی و غیر هوازی است. تشخیص اینگونه باکتری ها با افزودن یک قطره هیدروژن پراکسید(H2O2) امکان پذیر است.
فروش محیط کشت کاتالاز تست آگار
محیط کشت های پرکاربرد دیگری نیز هستند که متاسفانه بررسی تمام آنها از حوصله این مقاله خارج است.
امیدوارم که این مقاله برایتان مفید بوده باشد. شما می توانید سوالات خود را در خصوص انواع محیط کشت در این مقاله مطرح کنید.
- - نشانی ایمیل شما منتشر نخواهد شد.
- - لطفا دیدگاهتان تا حد امکان مربوط به مطلب باشد.
- - لطفا فارسی بنویسید.
- - میخواهید عکس خودتان کنار نظرتان باشد؟ به gravatar.com بروید و عکستان را اضافه کنید.
- - نظرات شما بعد از تایید مدیریت منتشر خواهد شد